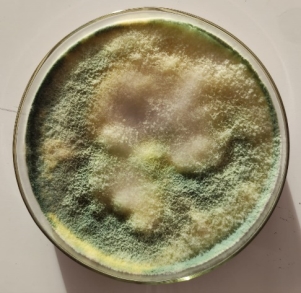
WhatsApp Image 2024-12-25 at 10.47.13
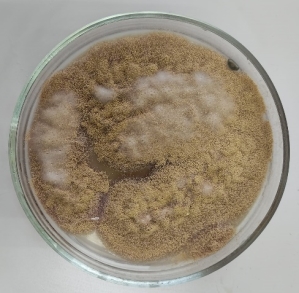
WhatsApp Image 2024-12-25 at 11.16.40 (1)
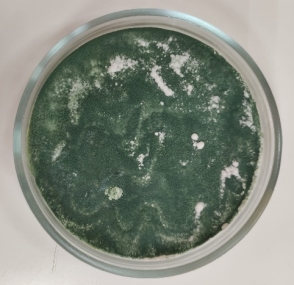
C:\Users\1\AppData\Local\Microsoft\Windows\INetCache\Content.Word\WhatsApp Image 2024-12-25 at 10.43.15.jpeg
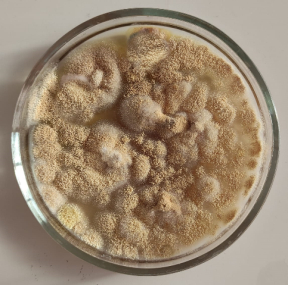
C:\Users\1\AppData\Local\Microsoft\Windows\INetCache\Content.Word\Рисунок1.png

В статье автор обобщает полезные биологические свойства триходермы и метаризиума, а также экспериментальным путем выделяет чистую культуру микроорганизмов на плотной питательной среде.
Ключевые слова: микропрепараты, грибы, природное земледелие, триходерма, метаризиум.
В природном земледелии для защиты растений от вредителей и болезней активно используют биологические микропрепараты, действующее начало которых энтомопатогенные и почвенные микроорганизмы.
Цель нашего исследования — выделить чистую культуру грибов Тrichoderma viride и грибы рода Metarhizium из биологических микропрепаратов для дальнейшего воспроизведения и применения в растениеводстве.
В своей работе мы использовали в качестве воспроизводимого микропрепарата «Триходерма вериде» производитель ООО «Ваше хозяйство» (Тrichoderma viride, штамм 471 ГНУ ВНИИСХМ РАСХН) и «Метаризиум Микс» производитель ИП Федоров Т.Ю (грибы рода Metarhizium).
Триходерма зеленая Тrichoderma viride — почвенный гриб, являющийся аэробным сапрофитом, активно воздействует на грибы из рода Bipolaris и Alternaria, а также является антогонистом бактерий, которые вызывают сосудистый бактериоз крестоцветных культур (бактерия Xanthomonas campestris pv. campestris (Pammel) Dowson).
В процессе жизнедеятельности триходерма выделяет целый ряд метаболитов, которые подавляют активность фитопатогенной микрофлоры.
Гриб стимулирует развитие на корнях азотофиксирующих бактерий, а также улучшает поглощение корневой системой микро- и макроэлементов.
Оптимальная температура для развития и размножения триходермы от + 22 º C до +34 º C. Она не оказывает токсикологическое воздействие на человека и животных. [3]
Грибы рода Метаризиум Metarhizium — почвенный энтомопатогенный гриб. Его также, как и триходерму можно встретить повсеместно.
Источником питания являются погибшие насекомые и хитиновый покров после метаморфоза. [4]
Метаризиум также атакует живые насекомые, прорастая в тело жертвы и вызывая заболевание «зеленая мускардина». Это микоз, который развивается в течении 4–10 дней с момента начала заражения. У инфицированных особей нарушаются процессы секреции слизи, рост и размножение. Они стремятся покинуть зону заражения. [5]
Этот гриб способен поразить около 200 видов насекомых-вредителей, которые обитают не только в почве, но и наземных частях растений. [4]
Токсикологическое действие на человека, а также на теплокровных животных и дождевых червей не оказывает. Не вызывает резистентности у насекомых-вредителей. [5]
По сравнению с химическими способами защиты, использование грибов в природном земледелии обладает целым рядом преимуществ:
— получение экологически чистой продукции,
— стимуляция роста и развития за счет биологически активных веществ, которые выделяют микроорганизмы в результате своей жизнедеятельности [1],
— обогащение почвы органикой и минеральными веществами в результате переработки растительный остатков [1],
— полное отсутствие химического ожога на листьях, цветах и корнях растений при использовании рабочего раствора микропрепарата даже со значительным превышением рекомендуемой дозировки.
— отсутствие резистентности у вредителей и патогенной микрофлоры. [5]
Залог успеха выращивания полезной микрофлоры в лабораторных и промышленных условиях заключается в стерильности оборудования, питательной среды и чистой культуры засеиваемых микроорганизмов. Последнего составляющего, зачастую, сложно достичь, так как на производстве микробиологических препаратов не всегда соблюдены технологические условия. В своей работе последствия таких нарушений мы часто наблюдаем. При выращивании грибов с использование в качестве исходного посевного материала промышленные биологические микропрепараты вместе с заявленным на пачке микроорганизмом высеваются дрожжи и другие незаявленные в составе микроорганизмы. Именно поэтому так важно вывести чистую культуру полезного гриба для дальнейшей работы по воспроизведению, наращиванию биомассы и непосредственному использованию.
Методика проведения эксперимента
Основные этапы эксперимента:
1. Посев биологических микропрепаратов «Триходерма вериде» и «Метаризиум Микс»
2. Выведение чистой культуры грибов.
Посев биопрепаратов и дальнейшее выделение чистой культуры грибов производились на питательной среде М9 с использованием в качестве источника макро- и микроэлементов универсального удобрения «Акварин».
Состав плотной питательной среды М9 [2]:
1 л дистиллированной воды
1,5 г универсального водорастворимого удобрения «Акварин»
20 г сахарозы
15 г агар-агара.
Стерилизация питательной среды происходила в воздушном стерилизаторе ГП-20-Ох-«ПЗ» 45 мин при 120°C.
Дальнейшие этапы работы проводились с использованием ламинарного шкафа. Питательную среду разливали в стерильные чашки Петри по 40мл, после чего производился посев грибов. Оптимальная температура выращивания грибов от + 22 º C до +34 º C. [3]. Оценку результатов проводили через 10 дней после посева.
Результаты исследования
Посев биологических микропрепаратов «Триходерма вериде» и «Метаризиум Микс».
Согласно вышеописанной методике результаты выращивания микробиологических препаратов в чашках Петри мы получили через 10 дней (рисунок 1).
|
|
|
|
Рис. 1. а) «Триходерма вериде» |
б) «Метаризиум Микс» |
На рисунке 1 хорошо видно, что загрязнение промышленных биопреператов посторонней микрофлорой присутствует. Из-за этого развитие триходермы и метаризиума угнетено.
Выведение чистой культуры грибов
Дальнейшая работа заключалась в выделении чистой культуры грибов из уже выращенных. Для этого мы произвели повторный посев с использованием в качестве посевного материала грибов из предыдущего опыта. Оценка результата производилась также через 10 дней с момента посева, как и в предыдущем опыте (рисунок 2).
|
|
|
|
Рис. 2 а) «Триходерма вериде», |
б) «Метаризиум Микс» |
При повторном посеве и отборе колоний грибов без посторонней микрофлоры из чашек Петри мы получаем чистую культуру, которую можно использовать в дальнейшем разведении (рисунок 2).
Таким образом, выделение чистой культуры на плотной питательной среде является важным этапом воспроизведения биологических микропрепаратов. Пренебрегая этим этапом, биопрепарат становится не только бесполезным в борьбе против вредителей и болезней растений, но даже опасным для человека из-за развития возможной сопутствующей патогенной микрофлоры.
Полученная чистая культура гриба применяется для массового воспроизведения и наращивания биомассы на жидких и твердых питательных средах с дальнейшим практическим применением в растениеводстве в качестве биологического средства защиты от болезней и вредителей.
Литература:
- https://metarhizin.ru/micro-organismes/trichoderma-viride/
- https://vuzbiochemi.elpub.ru/jour/article/view/334?locale=ru_RU
- https://www.pesticidy.ru/active_substance/trichoderma_viride_471
- http://prirodnoe-zemledelie63.ru/product/metarizin-50-g/
- https://biopax.ru/articles/metarhizium_anisopliae/